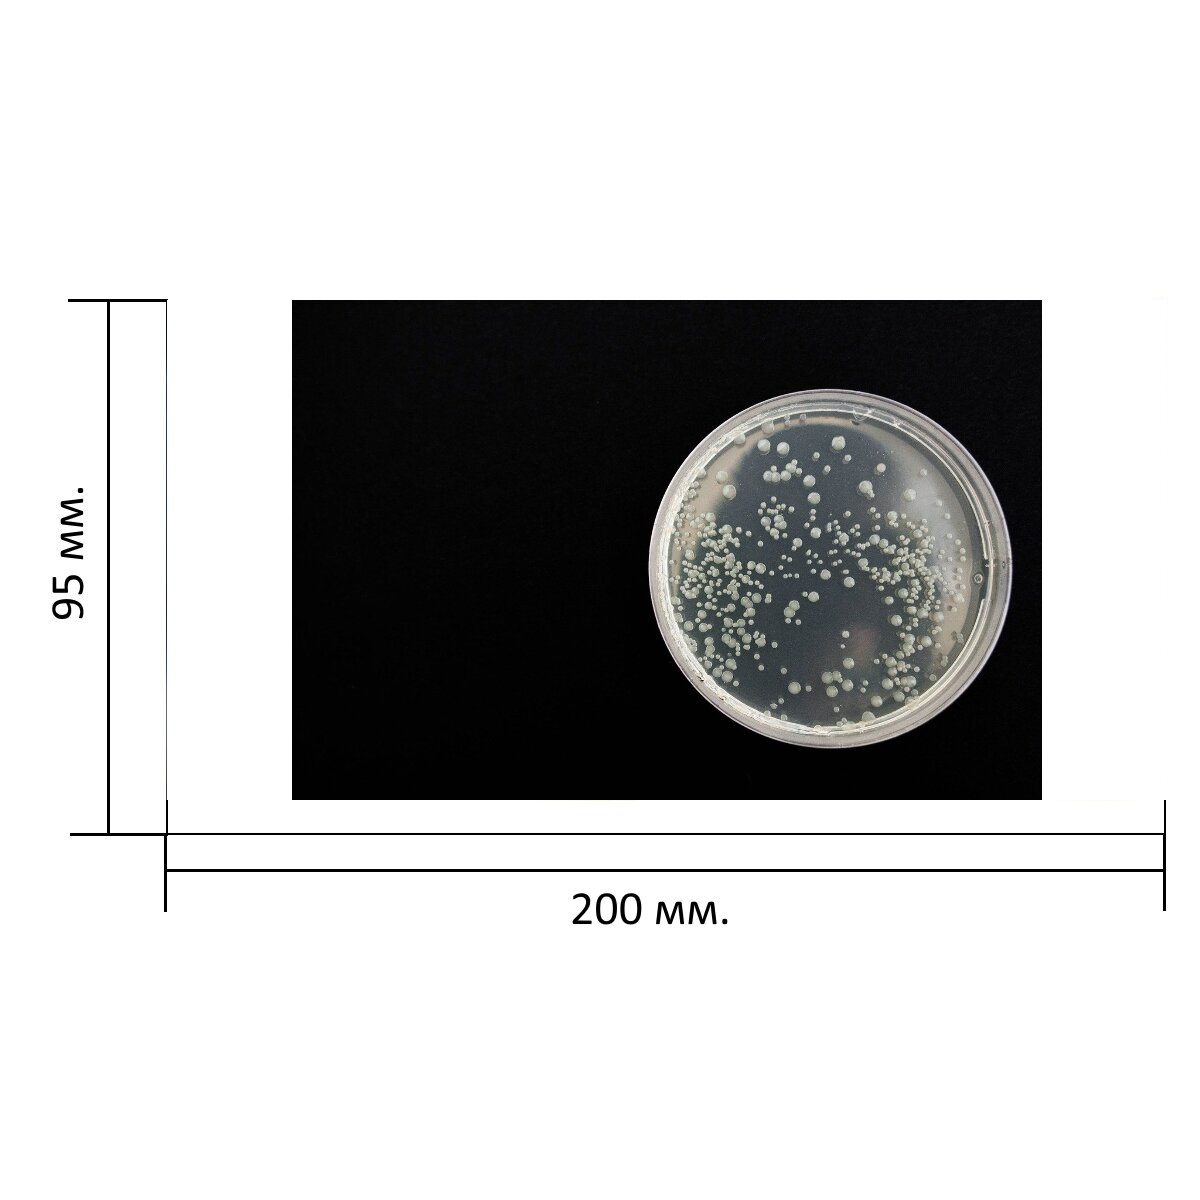

Описание
Представляем Вашему вниманию стильную и практичную кружку с ярким принтом "Бактерии, чернить, здоровье" объемом 330 мл. Этот незаменимый аксессуар станет отличным дополнением к повседневной жизни и прекрасным подарком для любого человека, ценящего комфорт и эстетику. Кружка изготовлена из качественной и прочной керамики, что гарантирует долговечность и сохранение первозданного вида изделия даже при постоянном использовании. Глянцевое покрытие придает кружке стильный и современный вид, делая ее идеальным аксессуаром для интерьеров в стиле минимализма или лофта. Рисунок на кружке выполнен с использованием стойких и безопасных для здоровья красителей, поэтому изображение сохранит свою яркость и четкость на протяжении долгого времени. Благодаря своему объему в 330 мл, кружка идеально подходит для горячих напитков, таких как чай, кофе или какао. Особенности кружки включают возможность мытья в посудомоечной машине и использование в СВЧ. Это делает уход за кружкой простым и быстрым, а также позволяет наслаждаться горячими напитками прямо из микроволновой печи. Подарите себе или своим близким возможность наслаждаться комфортом и стилем каждый день с нашей кружкой с принтом! Этот аксессуар станет незаменимым помощником в повседневной жизни и прекрасно дополнит любой интерьер.